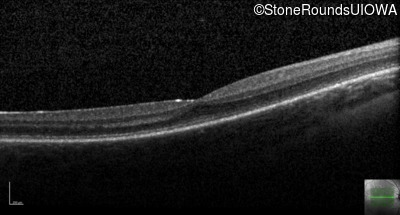
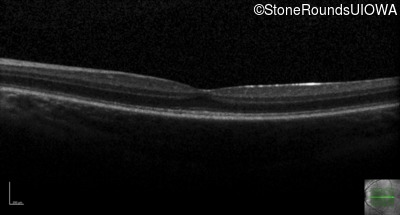

Case
SR27
Student Mode
Achromatopsia (IA2d)
Male
Male
Hidden
SR27
Student Mode
Achromatopsia (IA2d)
Male
Male
History
This 8 year old boy had nystagmus in the first year of life.
| Color Vision: | Correctly named 2/14 Ishihara plates OU |
|---|---|
| Refraction OD: | Plano +1.25 x 90 |
| Refraction OS: | -0.50 +2.75 x 80 |
Teaching Points
The clinical features supporting the diagnosis of incomplete achromatopsia in this patient include: nystagmus noticed in the first year of life; reduced acuity, poor color vision, a normal fundus appearance, a normal OCT, normally sighted parents and absence of a similarly affected male elsewhere in his mother's family.
Diagnosis & molecular findings
| Disease | Gene | Allele 1 variant(s) | Allele 2 variant(s) | Inheritance mode |
|---|---|---|---|---|
| Achromatopsia | CNGB3 | Thr383 del1aC | Thr383 del1aC | AR |